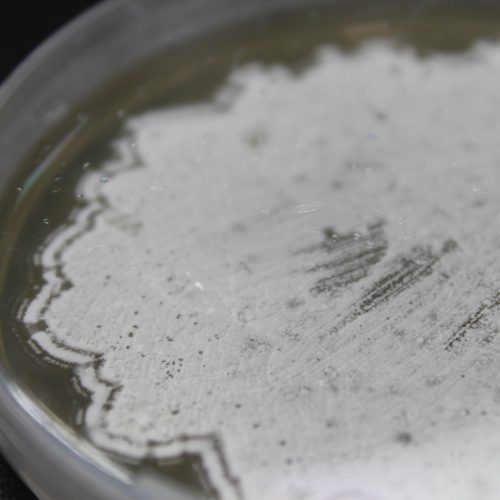

新入荷
再入荷
充実の品 山口 | 病原真菌と真菌症 英世 Amazon | 通販 | |本 医学一般
 タイムセール
タイムセール
終了まで
00
00
00
999円以上お買上げで送料無料(※)
999円以上お買上げで代引き手数料無料
999円以上お買上げで代引き手数料無料
通販と店舗では販売価格や税表示が異なる場合がございます。また店頭ではすでに品切れの場合もございます。予めご了承ください。
商品詳細情報
| 管理番号 |
新品 :62098139641
中古 :62098139641-1 |
メーカー | efe3f | 発売日 | 2025-06-07 01:30 | 定価 | 8310円 | ||
|---|---|---|---|---|---|---|---|---|---|
| カテゴリ | |||||||||

![[A11064284]消化器内視鏡第28巻2号 粘膜下腫瘍のすべて 消化器内視鏡編集委員会](https://auctions.c.yimg.jp/images.auctions.yahoo.co.jp/image/dr000/auc0410/users/d4fab30473777a8019148ae00533fa27693af6d4/i-img349x500-169833329968n8gx1003277.jpg)


![[A01708505]医学生のための検査医学 [単行本] 鳥海 純; 藤巻 道男](https://auctions.c.yimg.jp/images.auctions.yahoo.co.jp/image/dr000/auc0412/users/d4fab30473777a8019148ae00533fa27693af6d4/i-img349x500-17032546731ygy2e191429.jpg)
![[A01405228]内科研修マニュアル 慶応義塾大学医学部内科学教室](https://auctions.c.yimg.jp/images.auctions.yahoo.co.jp/image/dr000/auc0412/users/d4fab30473777a8019148ae00533fa27693af6d4/i-img366x500-1703244739jumt1e189791.jpg)

![[A11306535]眼科グラフィック 2017年2号(第6巻2号)特集:間違いやすい,判定しにくい視野障害とその病態 / ぶどう膜炎の画像解析 /](https://auctions.c.yimg.jp/images.auctions.yahoo.co.jp/image/dr000/auc0412/users/d4fab30473777a8019148ae00533fa27693af6d4/i-img382x500-1703617334d9w8bo275068.jpg)
![[A12183940]臨床精神薬理 第20巻11号〈特集〉持効性抗精神病薬治療の課題と新たな可能性 [単行本(ソフトカバー)] 臨床精神薬理編集委員会](https://auctions.c.yimg.jp/images.auctions.yahoo.co.jp/image/dr000/auc0411/users/d4fab30473777a8019148ae00533fa27693af6d4/i-img344x500-1700333441vpckup2413188.jpg)












